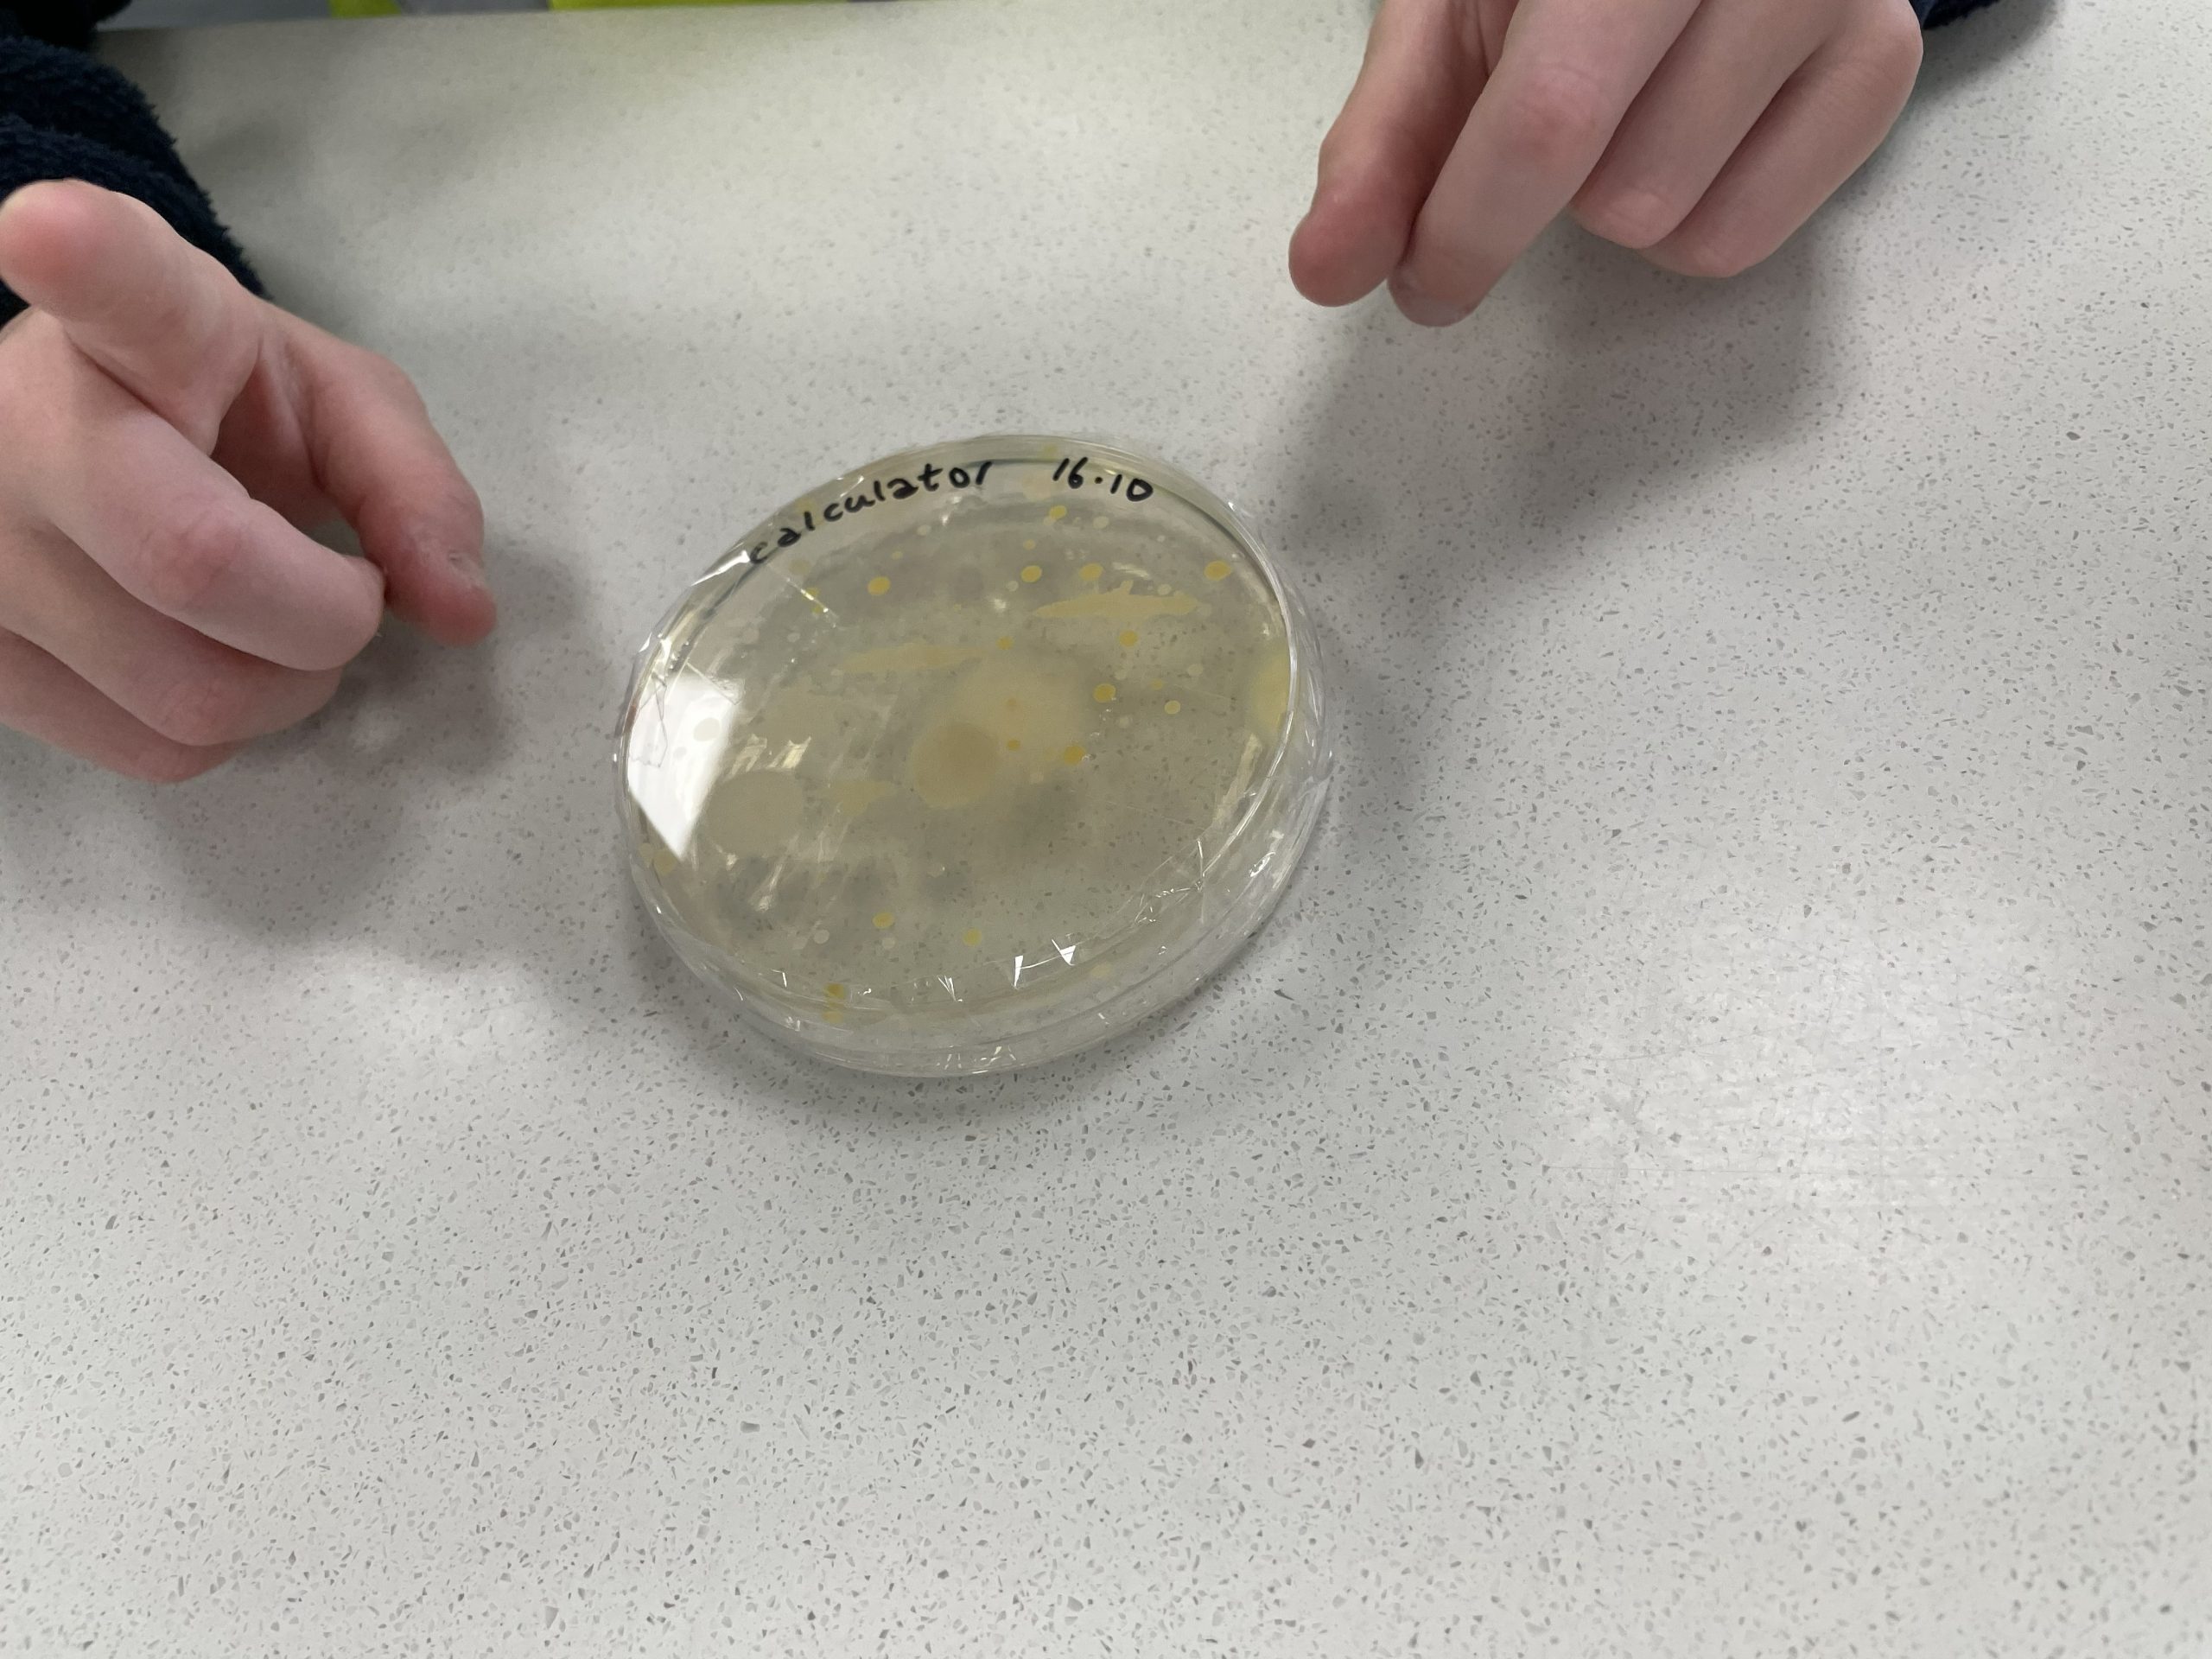
A petri dish

Our Environmental Health learners have recently been taking part in several important community outreach exercises!
Tutors Minakshi and Vicki ran a lab session for young students from Mead Vale Primary School. This session covered germs and how they can be found, where they appear most and how to clean them up properly. The group swabbed surfaces and then used ATP Meters to determine how dirty the swabbed area was. They also examined petri dishes with cultured bacteria from various surfaces, again showing which areas are dirtiest.
Additionally, Environmental Health apprentices from North Somerset Council hosted a stand offering housing advice, as part of a health promotion initiative. This was part of the ‘Wellness in Action’ event run by North Somerset Council. Over thirty organisations attended this event, helping people in Weston to boost their wellness over the Winter.
This event forms part of the subject Careers Excellence Hub. University Centre Weston has ten sector-specific Career Excellence Hubs, which evidence our dedication to supporting both employers and learners in achieving their future goals. By creating a seamless connection between industry and education, we enable learners to acquire not only the essential skills and knowledge but also the professional networks necessary to excel in their chosen fields.
Find out more about our Environmental Health courses by clicking here!

